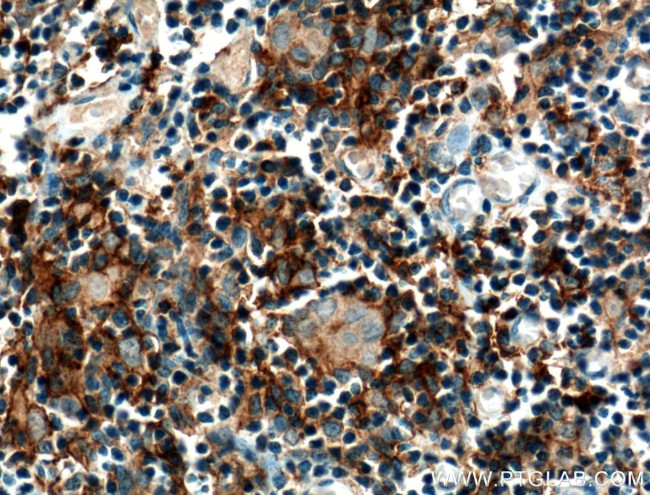
CCL25/TECK Antibody in Immunohistochemistry (Paraffin) (IHC (P))

Search
Proteintech
CCL25/TECK Polyclonal Antibody
{{$productOrderCtrl.translations['antibody.pdp.commerceCard.promotion.promotions']}}
{{$productOrderCtrl.translations['antibody.pdp.commerceCard.promotion.viewpromo']}}
{{$productOrderCtrl.translations['antibody.pdp.commerceCard.promotion.promocode']}}: {{promo.promoCode}} {{promo.promoTitle}} {{promo.promoDescription}}. {{$productOrderCtrl.translations['antibody.pdp.commerceCard.promotion.learnmore']}}
产品信息
25285-1-AP
种属反应
宿主/亚型
分类
类型
抗原
偶联物
形式
浓度
规格
纯化类型
保存液
内含物
保存条件
运输条件
产品详细信息
Immunogen sequence: QGVFEDCCL AYHYPIGWAV LRRAWTYRIQ EVSGSCNLPA AIFYLPKRHR KVCGNPKSRE VQRAMKLLDA RNKVFAKLHH NTQTFQAGPH AVKKLSSGNS KLSSSKFSNP ISSSKRNVSL LISANSGL (24-150 aa encoded by BC130561 )
靶标信息
Chemokines are likely to play an important role in regulating the trafficking of developing T cells within the thymus. Chemokine C-C thymus expressed chemokine (TECK), also designated chemokine ligand 25 (CCL25), small induc-ible cytokine A25, chemokine b-15 or CK b-15, is expressed predominantly in thymic dendritic cells, thymic epithelial cells and in the small intestine. TECK, a CCR9 ligand, has suppressive activity against immature subsets of myeloid progenitors which have been stimulated to proliferate by multiple growth factors. TECK delivers signals through CCR9, which is important for the nav-igation of developing thymocytes. Bone marrow pre-pro-B cells and cells capable of generating pro-B colonies in the presence of interleukin-7 and Flt-3 ligand migrate to TECK, a response lost in later stages of B cell development.
仅用于科研。不用于诊断过程。未经明确授权不得转售。
生物信息学
蛋白别名: C-C motif chemokine 25; chemokine (C-C motif) ligand 25; Chemokine TECK; SCYA25TECKvar; small inducible cytokine subfamily A (Cys-Cys), member 25; Small-inducible cytokine A25; TECKMGC150327; thymus expressed chemokine; Thymus-expressed chemokine; unnamed protein product
基因别名: CCL25; Ck beta-15; Ckb15; SCYA25; TECK; TECKvar
UniProt ID: (Human) O15444
Entrez Gene ID: (Human) 6370